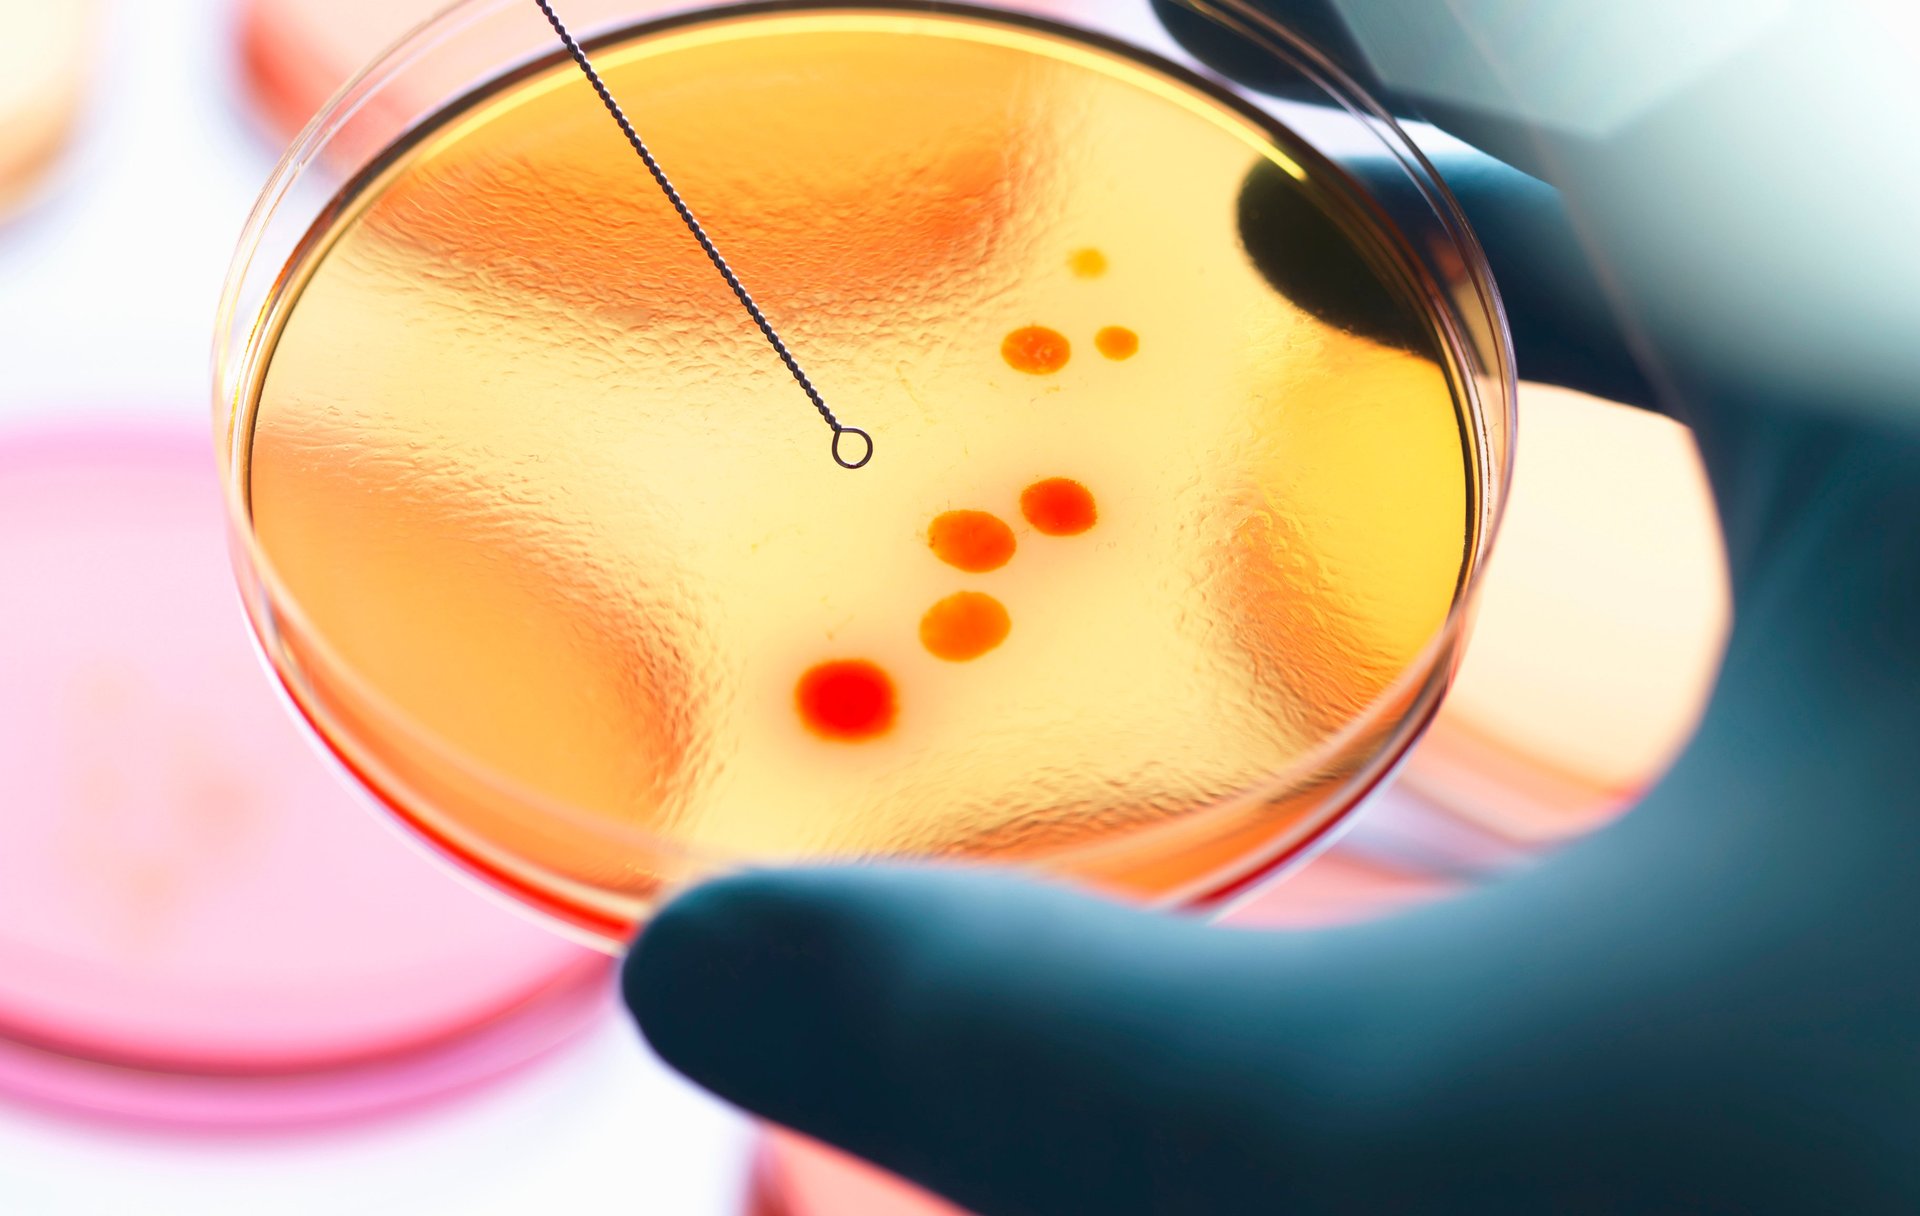

It is too early to draw many firm conclusions, but it seems reasonable to suggest that current global events are further highlighting serious fault lines in the legacy model of capitalism. One of the widest and deepest relates to the idea that a company’s sole responsibility is to make profit. New organisational structures and social constructs are emerging. This focus on shareholder profitability to the detriment of anything else is now being challenged like never before. The consumers and shareholders of the future seem likely to have very different values from those that preceded them.

All investment strategies have the potential for profit and loss. Past performance is not a guide to future returns.
Scottish Mortgage looks to provide long-term support to the companies and leadership teams that are at the vanguard of navigating this shift. As the global economy navigated its way through the pandemic, we liaised with companies we owned to reiterate our long-term support, encouraging them to retain a holistic view of their societal responsibilities rather than worrying about the smoothness of their short-term profitability. We hope that this support has helped them to remain resolutely focused on navigating this era of great societal and technological change and acting in the right way.
Scottish Mortgage is a highly unusual FTSE 100 constituent in the sense that the Company’s direct operational footprint is minimal. It employs six non-executives who formally meet six times a year.
The Company’s strength of governance is best reflected in the long-term returns that have been enjoyed by shareholders both over the last century and the last decade. These returns have been accompanied by the uninterrupted payment and growth of dividends for over quarter of a century.
Governance also needs to be considered in the context of the philosophy that underpins the management of the Scottish Mortgage portfolio, and the resulting holdings.
The Scottish Mortgage portfolio is managed with an exceptionally long-term mindset, with stocks held for around a decade on average1. The managers take a very selective approach, with a focus on companies that have the opportunity to grow to many multiples of their current size. More often than not, the companies with the most exciting prospects are those that seek to tap into technological and cultural progress to find newer and better ways of producing the goods and services that society will need over the course of the next decade. In this context, the managers’ approach to governance and sustainability is based on the following beliefs.

Governance is about maximising upside opportunity more than mitigating downside risk
The vast majority of long-term wealth creation within the equity markets comes from a very small number of companies – outliers with extreme returns that grow to many multiples of their original size. The companies and technologies that are able to facilitate society’s transition to a more sustainable footing are increasingly likely to feature strongly amongst the outliers. Their success will displace swathes of outdated incumbents. Those that seek to drive down costs and improve outcomes in fields such as healthcare and energy are most likely to count themselves amongst the big winners. The need to create a more sustainable global economy represents a huge opportunity for companies across the world. The stocks in the Scottish Mortgage portfolio therefore require approaches to governance that will maximise their chances of executing on the opportunity. In this sense, good governance is about maximising the chance of a very good company being a truly great company rather than a simplistic exercise in monitoring ‘best practice’ hygiene factors or mitigating downside risk.
Strong governance and exceptional shareholder returns go hand in hand
We believe that a company cannot be financially sustainable in the long run if its approach to business is fundamentally out of line with what society expects of it. Therefore we look to hold companies that are on the front foot in addressing questions about their supply chains, their labour practices, their societal responsibilities, their environmental impact and their resilience to a world of properly priced carbon. In the long term, companies that abuse the environment, treat staff poorly or cause damage to the fabric of society risk being regulated out of profitability or deserted by their customers. Consideration of such factors must therefore form an integral part of any credible long-term investment process. In contrast to many within our industry, we do not consider strong environmental and social governance to be a badge or an optional add on.
Context matters. Labels, metrics and box ticking are unhelpful
We also believe that the ‘correct’ governance model for an early-stage entrepreneurial growth company is likely to be very different to the model that might be required for a mature and sizeable incumbent. The need for a company to have regard to its social impact scales with the length of its supply chains and the number of customers and employees. In both the private and the public markets, governance priorities are different from company to company, and they evolve over time.
We believe that no amount of quantitative filtering can adequately capture this dynamic. The most important issues are usually the most complex, and they tend to be highly qualitative. Numerical indicators need to be approached with extreme caution. In this vein, we focus on outcomes rather than obsessing over metrics and box ticking. Sadly, counting what can be measured has become central to the broader ‘ESG’ agenda for all too many. This is a dangerous trend. Good governance is not about metrics. It’s about creating enduring companies and helping societal advances – and is much more complex than the simplistic models some ESG ratings agencies suggest.
Long-term engagement is usually more influential than proxy voting
Perspectives on governance are best formed over time. By thinking in decades rather than quarters we form enduring relationships with the companies in which we invest. Long-term engagement therefore sits at the heart of our approach to governance. We have a responsibility to support and back advances and improvements over time. This is a marathon, not a sprint, and an endeavour which extends well beyond sending a letter to a company and expecting an instant response. It is also about focusing on the issues that are most material and relevant, rather than those which happen to be in the media spotlight at any point in time. We look for thoughtful measures of system-wide progress rather than quantitative snapshots of individual companies. Perversely, in the world of tick-box governance, the very act of only investing alongside the world’s best management teams can lead long-term stock pickers to be marked down by external governance scorers who may criticise them for not opposing enough proxy votes. Within the Scottish Mortgage portfolio, we are less likely than some others to oppose management through proxy votes because we look to invest only in companies where we think we share values and horizons in the first place. We see little merit in investing in companies where we know we will have to constantly battle short-term management decisions to achieve good outcomes for shareholders in 10 years’ time.
External eyes are more valuable than industry introspection
We believe that socially and cognitively homogeneous members of the financial services industry are ill placed to issue decrees of the critical governance and sustainability issues of our times. Instead, we place much more value on the views of experts from outside our industry as we seek to calibrate our holdings’ responses to the challenges and opportunities at hand. We have found perspectives from Carlota Perez, the Long Now Foundation, Johns Hopkins, and the Universities of Sussex and Tsinghua to be particularly helpful. We are firmly of the view that no single governance topic has ‘an answer’, but synthesising these perspectives helps us to engage with portfolio holdings as we support their efforts to steer the most appropriate path.
Having set out our approach and core beliefs, the remainder of this report aims to provide a sense for how the Company and the underlying portfolio are positioned to navigate some of the most pressing governance and societal issues at hand.
The climate crisis is anthropogenic and represents an existential threat to humankind. The exponential nature of the damaging consequences is being seriously underestimated. In contrast to many in the corporate world and the finance community, we don’t believe that humankind has the luxury of a few decades to make the necessary radical changes. The actions of the next five to 10 years are crucial because they will dictate subsequent emissions levels for decades.
In the rush to come up with ‘solutions’, short cuts are being taken and important context is being lost. By way of example, we don’t consider carbon foot printing to be especially helpful. That some firms pollute more than others is a mostly meaningless observation, so we place little emphasis on the carbon intensity of the Scottish Mortgage portfolio, even though, when measuring the public companies in the portfolio, it is approximately 95 per cent lower than the global index2.
More helpful is the observation that Scottish Mortgage is in an exceptional position to deploy patient capital into innovative new technologies with the potential to accelerate the transition away from carbon. The climate crisis requires a focus on exponential solutions. Tesla is a case in point. This company has had an outsized impact on decarbonising the global economy by vastly accelerating the electrification of the automotive industry. As Tesla’s largest single underlying external shareholder for much of the past decade, Scottish Mortgage is enormously proud of the role it has played, by supporting Tesla throughout periods of extreme volatility3 and scepticism from many quarters, particularly in the early days when operational success was far from assured.
There are 25 companies within the Scottish Mortgage portfolio tackling the climate crisis with exceptional levels of ambition and scale. Examples beyond Tesla include:
– NIO – a manufacturer of premium electric vehicles in China
– Solugen – a synthetic biology company aiming to decarbonise the chemicals industry
– Northvolt – who are striving to create the world’s greenest battery cell
– Climeworks – developing and commercialising the concept of direct air capture – a technology which seeks to remove carbon dioxide from the atmosphere
– Upside Foods – a frontrunner in the cultivated meat industry who are aiming to provide a more environmentally friendly source of animal free meat
– Lilium and Joby Aviation – electric aircraft
But the opportunity associated with the climate transition extends further. Farsighted companies operating in consumption-led fields also have a tremendous opportunity to lead with new business models and new corporate mindsets. Kering is a good example. Our conviction in the long-term opportunity for this fashion company is reinforced by the fact that it has set out to be a role model, with an industry-leading level of carbon transparency, ambitious carbon reduction goals which relate to 2025 and 2050, and a pioneering environmental profit and loss account. Our engagement with Kering, over many years, has highlighted the extent of the company’s positive advocacy and its work with others to ensure the traceability of its raw materials. Kering’s recent release of a comprehensive biodiversity strategy, underpinned by environmental profit and loss account data, is a pioneering move on an issue only beginning to appear in the wider corporate consciousness.
In contrast to the opportunities described above, we believe that fossil fuel companies face decades of structural challenge. We have found no opportunities in this area and, as such, the Scottish Mortgage portfolio contains zero exposure to fossil fuel stranded assets.
Over the past year, we have been undertaking a series of discussions with companies to better gauge their attitudes and adaptability in relation to climate issues. Our approach is not to be constrained by obvious, risk-based assessments of materiality, but to be open-minded and to support each company as it finds its own advantage and influence through the transition.
Some recent examples follow:
Opportunity
NVIDIA’s overriding aim is to improve the energy efficiency of graphics processing units (GPUs) and data centres. In addition to this core purpose, a key challenge is whether it can access enough ‘green’ components over the next decade to satisfy the demands of its increasingly aware customer base, and whether this could become a point of competitive edge and/or premium pricing.
Attitudes and operations
Chief financial officer Colette Kress has discussed sustainability with us. This speaks to the importance of environmental considerations to NVIDIA and backs up its strong track record in reporting and climate engagement. The firm currently sources 25 per cent of its electricity needs from renewables and aims to increase this to 65 per cent by 2025. The reduction target for direct emissions is judged to be 1.5C-aligned. Next, NVIDIA is keen to increase coverage of value chain emissions, with expansion across upstream manufacturing and downstream product use/disposal as a priority for 2022. It needs to engage with its own suppliers and customers for better data. Once the company has more confidence in the figures, it intends to set a wider value chain net zero target.
Influence
As NVIDIA gathers more scope 3 data, it will be interesting to see how it develops these targets and to monitor the additional supplier engagement that it promotes. NVIDIA is a member of the Responsible Business Alliance, which verifies that the firm engages with all of its major suppliers on energy, waste and water use. While all provide NVIDIA with data, the quality and extent are not good enough and this is a key area for it to influence and work on.
Next steps
NVIDIA plans further work in relation to waste management and end-of-life recycling/re-use. We will monitor this closely because in our view it could be an increasingly important influencer of design choices. That presents the company with a very large opportunity.

Opportunity
By advancing the lithography machines that print tiny patterns on silicon wafers to create computer chips, ASML sits at the heart of semiconductor manufacturing technology, and underpins the continuation of Moore’s Law. While its machines are increasingly power hungry, they enable products that allow greater energy and resource efficiency.
Attitudes and operations
ASML reports its scope 1 and 24 emissions. Its ambitious target for net zero direct emissions by 2025 will require the greening of natural gas for direct combustion and the production of hydrogen. Our engagement with the company has focused on this goal and its strategy of purchasing renewable energy certificates (RECs) to cancel out its remaining electricity-related emissions. A question it faces is whether to continue as a remote purchaser of RECs, which carries the risk of a price squeeze. The alternative is to become a direct investor/purchaser. It has already invested in hydro in Norway and is adding local solar.
ASML began reporting scope 3 emissions in 2019 and refined the report in 2020 to include estimates both up and downstream. It acknowledges that this is still a work in progress and has made a public plea to those in its value chain to accelerate their own reporting. This applies not only to electricity for manufacturing and cooling, but also to water, to hydrogen and to the fluorine-containing gases SF6 and NF3, which are both aggressive warmers from a greenhouse gas perspective.
ASML has a transparent target for 2025 with scope 3 emissions rising to 11.9Mt, but revenue-based intensity to drop by 20 per cent to 0.5kt/million euros. This goal is based entirely on improving the efficiency of its lithography machines, but it makes no assumption about any change in the electricity grid mix of the customers using the machines.
Influence
We have had some helpful discussions with ASML about key actors within the supply chain. It notes the importance of statements and ambitions of its customers’ key customers, such as Apple, which, in ASML’s opinion, adds a climate clarity and focus to the whole ecosystem. In our view, ASML’s reporting, targets and narrative stand out well. It is one of the few companies in our portfolio (indeed the market) to have a pre-2030 net zero target for direct emissions, and yet it knows it must do more.
Next steps
We will continue to reflect on how properly costed resources, such as energy, water and fluorinated greenhouse gases (F-GHGs), might disrupt the semiconductor supply chain. The global system seems highly efficient today, but that might not be the case in a world of costed natural resources, a scramble for green power, and greater concerns regarding access and national security. We will also continue to explore the physical risks of climate change, both in terms of disrupting access to fresh water – critical for the big chip fabricators – and the 30-to-40-year outlook for sea level rises and flooding.

Opportunity
As a leading provider of housing finance in India, HDFC could exert extensive influence and leadership. Its biggest opportunities lie in accessing green-linked finance, and the customer loyalty that should come from being climate positive by means of funding sustainable housing.
Attitudes and operations
HDFC acknowledges climate risk, predominantly as a physical issue. It is committed to net zero but has not yet given a date. The company’s climate reporting is very limited and there is much work to do. By way of example, there is no direct link or target for lowering the emissions intensity of the assets it lends against, nor is there any detail regarding potential losses from physical climate change.
One of HDFC’s key attractions has been the quality of its lending standards. It’s encouraging that environmental factors feed into its decision making on this front. For example, the company recently declined to lend to developers around lake, coastal and mangrove areas on environmental grounds.
Influence
HDFC has just begun some limited pilot reporting of its own emissions. We need to check the data, and the next step is clearly a reduction target. But this is housekeeping relative to the need to influence both the siting of new builds and energy efficiency standards in construction. To assist, we have shared examples of what other banks are focusing on. HDFC could lead by example – ahead of formal requirements from the Reserve Bank of India, which joined the Network of Central Banks and Supervisors for Greening the Financial System in April.
Next steps
The most business-critical climate issue for us as investors is HDFC’s physical risk exposure. This involves how its executive team and its arguably somewhat static and over-burdened board get up to speed with local climate science. Overall, HDFC is engaged and aware. But it’s still at the early stage of collecting information and forming a strategy. It could exert material influence on regulators, developers and customers that could impact the pace of India’s wider emission cuts. It could also be more dynamic in adding interest and expertise at board level, and stronger at leading best practice.
We will also monitor the progress of green housing loans. We have advised HDFC to become a leader in this area.
Opportunity
Adyen’s revenues and operational footprint are still relatively small. But as a payment platform with a global merchant base, it has an interesting opportunity in regard to its role in purchasing decisions that collectively have a substantial carbon footprint.
Attitudes and operations
In 2019, Adyen back calculated all its direct emissions to date. It chose a company called South Pole to facilitate a number of international offset projects to match its historic and ongoing emissions. Based on our research, the cost of its offsets tends to be in the $15-20/tCO2e range. While this is less than half the current cost of carbon within the EU and way below the long-term required cost of carbon, it is a helpful start. Done well, voluntary carbon offsets can route funds to low-cost mitigation projects with wider social benefits. Adyen doesn’t yet have targets for direct emissions reduction but accepts that offsets alone aren’t the answer.
Influence
A new initiative involves a carbon calculator that enables the customers of its merchants to offset the approximate footprint of their purchases at the point of purchase interface. Proceeds are then routed to South Pole offset projects. It’s currently unclear how much of Adyen’s scope 3 emissions might ultimately be routed through from consumers using the new purchase offset app. So far only one supermarket has joined the programme, but others are talking about doing so.
Next steps
The point of purchase offset initiative is one to watch. It speaks to the potential influence that ecommerce platforms could have on purchasing behaviours.
It is worth noting that some companies need a little more help and support. Wayfair is a case in point. This online home furnishing platform has a huge opportunity to positively influence the environmental and social supply chain, but its external communications and disclosures on this topic have been somewhat lacking. To this end, we have been speaking to the head of sustainability and government affairs. There is clear intent to progress in various areas, and to seek examples of industry best practice. We look forward to continuing the conversation and seeing concrete action.
Even the leaders in this area have potential for further improvement. Over the last couple of years we have been providing feedback to Tesla on its impact report. The company’s reporting of its environmental and social impact has improved considerably in recent years, and we encouraged Tesla to continue innovating. We suggested that more detail on operational emissions, corresponding reduction strategies, supply chain auditing and health and safety data, would be useful for shareholders. As responsible long-term stewards of the business, we look forward to further dialogue with the company.

Scottish Mortgage believes that access to the world’s greatest companies should not be the preserve of the middle class and wealthy. There is a huge opportunity to democratise the world of finance and improve access accordingly. The Company has a consistent record of sharing the benefits of scale with underlying shareholders by proactively reducing fees to the extent that, at around a third of one per cent, they are now very substantially lower than those of any peers.
This commitment to democratisation and access extends beyond the public markets. In recent years, the Company’s board has increased the level of access to private companies – a historically rarefied asset class accessible only through exclusive and expensive vehicles. Some governance considerations play out differently in private markets compared to public. In the case of primary capital investments, the funding goes directly to company balance sheets, enabling them to invest in future growth. As private investors, our access to these investments is often predicated on building strong relationships of trust with the management teams of these companies who, in turn, talk to each other. Periods of market stress and economic uncertainty present opportunities to deepen these relationships and amplify trust, all of which reinforces the enduring ability of our shareholders to access this type of asset class.
Similar democratisation and disruption are sorely required beyond the sphere of finance. The global pandemic shone a light on grave global disparities in access to other basic services such as healthcare and education. It has also hollowed out the creative arts in many countries. These issues risk becoming more acute in the years ahead. The businesses that improve access and outcomes whilst displacing bloated incumbents seem likely to thrive and find themselves amongst the outliers in terms of success.
In healthcare, much of the political debate around unequal access has focused on who should pay for treatment rather than why it is so expensive in the first place. But declining productivity sits at the heart of this social issue. With the return on healthcare research and development spend falling constantly and predictably for over half a century, it is abundantly clear that a new model is needed. In our view, technology sits at the heart of the grounds for optimism. The past couple of decades have seen a 30-million-fold reduction in gene sequencing costs – a direct result of the explosion of processing power and sequencing data that has largely been driven by Scottish Mortgage holdings ASML and Illumina respectively. Covid-19 has highlighted the critical social importance of such developments. It took two of the Scottish Mortgage holdings collectively four days to find a cure for the coronavirus: two days for Illumina’s machines to sequence the code, and two days for Moderna to plug the code into its software to produce the vaccine. Whilst the clinical trials process and vaccine roll out still took several months, these are transformational developments in a field where similar initiatives might have historically taken a decade. Other portfolio holdings offer the potential of similar revolutions – Tempus Labs, which has developed a small voice-enabled device allowing oncologists to access real time data and insights, and Zipline, whose autonomous drones deliver critical healthcare supplies to some of the world’s least accessible communities.
The operational and financial performance of these transformational forces will inevitably be volatile. From a governance perspective, the role of the Scottish Mortgage portfolio is to provide patient capital and long-term support rather than prescribing excessive structure or constraints at a critical stage in these companies’ lifecycles. In the context of Moderna, for example, our recent discussions have related to the remarkable change that the company has undergone in recent times. The Covid-19 vaccine has transformed the business from a clinical stage researcher to a commercial company executing at scale. Through our frequent conversations with CEO Stephane Bancel and the broader leadership team, we have therefore sought to both offer support and to understand how the company’s culture will be preserved. Bancel is a strong believer in the importance of an exponential mindset. He encourages colleagues to think in multiples rather than in incremental terms. Preserving the science-driven culture will be critical as Moderna scales. Bancel speaks of the people that he has hired with justifiable pride. He ventures that part of the company’s secret sauce is that the head of manufacturing, Juan Andres, and Stephen Hoge, who leads R&D, sit next to each other rather than being siloed in different departments. “If you have great research but the manufacturing teams don’t talk to the scientists, you might have great publications in nature, but you won’t have a product.” We look forward to continuing these conversations over the coming years on the basis that Moderna has a growing chance of being one of the most societally important companies in the world.
Beyond the field of healthcare, similar fissures are emerging within the global education system. In Britain and overseas, access to top universities remains largely the preserve of the wealthy. Others emerge with crippling debts and with qualifications whose relevance atrophies quickly against a backdrop of accelerating automation and technological progress. The portfolio’s holding in Udacity helps to solve this problem by transforming access to education around the world. Udacity’s online learning courses and ‘Nanodegrees’ are helping to equip and retrain the global population for careers of the future at less than one-tenth of the costs of a traditional university education. So far, 10 million students from 160 countries have taken Udacity’s courses and there remains vast potential.
Music is another industry which has historically been beset by bloated incumbents – with slim pickings for the underlying artists themselves. Record labels have tended to capture over half of the money spent on music globally, with artists receiving, on average, just 17 per cent of total sales. But Spotify is redefining the music industry’s value chain, from creation to distribution to promotion. In so doing, the company is gradually eroding the stranglehold of the labels while giving more to artists. This should ultimately lead to the economics moving closer to those of the two-sided platform that it aspires to become. Daniel Ek, the visionary founder, is incorporating a range of services to help with this aspiration. Anchor, the free, one-stop shop for podcasting is amplifying the voices that, for technical or financial reasons, may have been underrepresented in the past. Soundtrap is Spotify’s collaborative, web-based, audio recording and production studio. These tools have been especially critical in supporting artists during lockdown, and their value to artists has been bolstered by Spotify’s Covid-19 Music Relief project, which has provided financial support to those most in need within the global music industry. Spotify’s long-term aspiration is to enable a million creative artists to live off their art, and we have been engaging with the company to better understand how the business plans to monitor progress against this core mission.
Around 90 per cent of the data generated in the history of humankind has been created in the past two years, but we remain of the view that the data revolution is just beginning, underpinned by a number of Scottish Mortgage holdings. The technology of ASML and NVIDIA is driving continued advances in chips and connectivity, whilst the SpaceX Starlink broadband service promises to connect billions more devices in the coming years. The associated opportunity for humankind is clearly vast: unprecedented democratisation of access accompanied by vastly improved resource efficiency across the economy. But the way in which companies decide to collate, moderate and utilise their data will determine their ‘social licence to operate’ and, in turn, their long-term investment prospects.
A number of larger data platforms have grown used to inherently borderless platforms, but they are now interfacing, and often colliding, with numerous regulators and governments around the world, initially in western economies and most recently in China as well. Data governance goes beyond simple compliance with increasingly stringent data security and privacy regulations, so we have been working closely with holdings to understand their approach.
Over the past couple of years, our conversations with the management teams of Alphabet and Facebook have led us to conclude that these companies will continue to face ongoing challenges around content moderation and privacy. We therefore sold both holdings. Whilst regulation may entrench the positions of powerful incumbents by slowing down innovation and impeding company creation, it is also likely to cap their returns from here. We continue to reflect on the implications for other large platforms such as Alibaba and Tencent.
As we look to learn more about this complex area, we continue to draw upon partnerships with institutions such as the Leverhulme Centre for the Future of Intelligence, Delft University of Technology and Tsinghua University in Beijing.
We strongly believe that prescribing conventional board structures is unhelpful. It is notable that, without exception, Scottish Mortgage’s most successful investments have been in companies with unconventional governance structures. Over the years, many of them have had to resist pressure from certain shareholders and proxy voting agencies demanding that they conform to corporate governance ‘best practice’. Had they acquiesced to such demands, they would, almost certainly, have ended up being mediocre in terms of their impact and their returns to shareholders.
We also believe that there is no ‘one size-fits-all’ model. The governance structures that work for one holding might be wholly inappropriate for another and this is particularly true of the holdings within the Scottish Mortgage portfolio given the range of ages, stages and operational footprints.
We do, however, look for some important common traits from a governance perspective.
Patience and purpose
This entails a sense of core purpose that extends beyond making profits. John Kay, erstwhile member of the Scottish Mortgage board, has written at length about obliquity – the principle that complex goals are best achieved indirectly. Just as the happiest people aren’t necessarily those who focus on happiness, and the most successful cities aren’t planned, the most profit-orientated companies aren’t usually the most profitable. It follows therefore that one of the most important elements of governance entails supporting companies in fulfilling a clearly defined long-term purpose. This extends to mean backing the management teams that are willing to defer near-term profitability by focusing capital on the long term. It is no coincidence that the companies in the Scottish Mortgage portfolio spend far more on measures such as capital expenditure and research and development, than they do on short-term stock market pleasing measures such as buybacks and dividends.
((CAPEX – Depreciation) + R&D) / (Gross Buybacks + Dividends)

This tends to make them more volatile in the short term but more resilient in the long term. The associated periods of volatility are typical of the most adaptable companies. The holding in Chinese electric vehicle company NIO was a case in point, in 2020 the share price fell to less than a quarter of its IPO price 18 months earlier, before then rising twenty-five-fold. Such moves tend to represent more noise than signal, but they can present the most wonderful opportunity – to not only buy more shares but also to strengthen relationships with company management teams.
Well-Governed growth and scale
Many of the companies within the Scottish Mortgage portfolio are growing rapidly. As they scale quickly, we have been engaging closely in order to understand how their cultures will be preserved and strengthened.
An example in this vein is Adyen, whose headcount has more than doubled over the past couple of years, in large part under remote onboarding conditions. CEO Pieter van der Does took the view that it was appropriate to ramp up hiring. The long-term opportunity had increased and Adyen faced an influx of talented people looking for work. But critically, the company maintained its cultural controls of ensuring that every new hire was interviewed by a board member. That involvement in the final stages acts as a quality control mechanism for corporate culture, but also team dynamics and leadership. Hands-on involvement in recruitment and training therefore remains a priority when the founders and the rest of senior management are allocating their time, and we are very supportive of this approach.
Larger and longer-established holdings face different challenges, but one of the many benefits of engaging as shareholders over long periods of time is that we can contextualise and prioritise the issues at hand. Amazon is a good case in point and, over the past couple of decades, we have engaged with the company on many different topics.
Amazon Engagement

Starting with a discussion about the AGM agenda in 2009, conversations have broadened to cover areas as wide ranging as remuneration, shareholder rights, employee working conditions, tax, environmental footprint and board diversity. We have discussed Amazon's hesitancy to publish certain practices if they are not deemed pre-eminent and, in this vein, we have been encouraging Amazon to lead from the front, reiterating our desire for the company to publish more granular health and safety data on its workforce. These exchanges have been challenging but respectful and are two-way. They help us gain insight into ‘management quality,’ as well as demonstrating to management we act as sensible, long-term, pragmatic, supportive shareholders. There are still conversations ahead of us, but with time, respect and trust, we hope our challenge to the company on the management of risks, will allow it to take full advantage of future growth opportunities.
We have been discussing similar topics with Robyn Denholm, the chair of Tesla. While there is still stakeholder scrutiny of Tesla's approach to some ESG issues, including employee arbitration rights and supply chain risks, we are encouraged by the excellent progress that the company has made over recent years with respect to external disclosure and impact reporting. Part of the progress here links back to the increased strength and depth at Tesla in the team surrounding Elon Musk – an evolution that we feel is largely overlooked. Our impression is that Tesla has moved from a culture of an idiosyncratic founder to a firm that has the management and resources to be self-reinforcing and sustainably different. This has been accompanied by increased stakeholder engagement, and the recruitment of new independent directors such as Hiromichi Mizuno, brings additional board level oversight to Tesla's approach to governance and sustainability issues.
For Meituan, the Chinese online commerce platform, scale brings different challenges. There are an estimated 200 million flexible workers in China. More than five million of them earn a form of income from Meituan. In recent years, we have been engaging with the company in relation to wages and working conditions for their delivery drivers. Meituan covers the riders’ personal accident insurance but social security is a more complex issue given differing local policies. Companies such as Meituan are not only having to remain nimble amid a changing competitive landscape and new threats of disruption, but must also be alive to the changing regulatory climate.

Adaptability and cognitive diversity
The Scottish Mortgage board, chaired by Fiona McBain, currently comprises six members. Each of the non-executives appointed by Scottish Mortgage brings extensive experience from different spheres of science and commerce.
The imperative for cognitive diversity extends to the portfolio holdings. The technological revolution that is being embraced within the Scottish Mortgage portfolio transcends boundaries and borders (despite the best efforts of some global leaders to resurrect them). As a result, the employees and customers of the stocks within the portfolio have unprecedented levels of social, ethnic and cultural diversity. In order to be successful, the holdings need to be sensitive to, and to adapt to, this changing world. We consider cognitive diversity to be a crucial underpinning of adaptability, but it is a largely qualitative assessment and we shy away from any suggestion that there can be a best practice ‘model’. Metrics can be a starting point, but they provide no insight into the quality of debate, discussion and decision-making.
A diverse board recognises that a lack of diversity can result in lost opportunities, and this is the case with Illumina. This company has a stated mission to improve human health by unlocking the power of the genome. Currently, despite differences in race, gender, background, diet and a multitude of other factors, treatments for diseases are similar for all patients. Genomics is about understanding diversity by analysing an individual’s genome and using this information for personalised diagnosis, disease management and treatment. Extremely large and diverse data sets are needed to provide context for interpretation of genetic sequences. Illumina has realised that success in genomics requires a nimble organisation willing to move beyond its borders. CEO Frances deSouza is of Greek and Ethiopian heritage; he grew up in the Middle East then relocated to America to study. In recent years, he has broadened out the executive team by including more ethnic minorities and individuals from business backgrounds outside the medical arena. Illumina has broadened its geographic reach by employing staff of different nationalities in offices across the globe, careful to be sensitive to local operating environments and not impose an American approach in local markets. To ensure that such sensitives became part of the DNA of the company, Illumina brought in a chief people officer with a wealth of experience outside biotech. The company also appointed a director of global diversity and inclusion to help focus and formalise efforts in diversity within the organisation. Additionally, Illumina has become active in clinical consortium research programmes such as the iHope Network5 to provide sequencing and gather data from groups that have historically been underserved and underrepresented due to background or diagnosis. By doing so, the public wealth of knowledge will continue to grow and provide benefit to many more patients who depend on the precision of genomic medicine.
With an audience spanning almost 200 countries, Netflix is another portfolio holding that understands that its employees need to reflect the world with a wide range of perspectives and backgrounds. But this effort is focused away from box ticking and quotas and towards creativity. In the last few years, we've seen Netflix invest heavily in storytellers that reflect the diversity of its audiences. Lebanese director Mir-Jean Bou Chaaya’s Jinn is the first Arabic-language original series, a supernatural thriller based on Islamic mythology. Dee Rees’ Mudbound depicts the struggles of two young men, one black and one white, who return from the war to work the land in the American South. These stories and their creators demonstrate that provisions and clauses are not the only means to necessitate diversity and plurality of expression. Netflix’s underlying belief that diversity of thought, culture, background, and perspective is the only way to create a truly global entertainment network and sits at the heart of the company’s long-term advantage. This is not to suggest that the journey has been straightforward and nor is it complete. Since Netflix fired its chief communications officer for racial insensitivity, the company has hired a vice president of inclusion strategy to help devise and implement strategies that integrate cultural diversity, inclusion and equality into all aspects of Netflix’s operations worldwide.

The examples throughout this report are representative of the Company’s approach to governance and sustainability, but they are far from exhaustive. We hope they illustrate the role we play in providing significant and enduring support to the small number of companies that are driving transformational change. In this sense, we are true impact investors.
We are privileged to enjoy deep and enduring relationships with some of the world’s greatest management teams. Our role is to ask questions and often to foster helpful links between them. Acknowledging that great governance is not about prescription or measurement might be one of our greatest advantages in our quest to find, fund and back genius. We look forward to sharing more examples of these ongoing conversations in the decades to come.
Scottish Mortgage Annual Past Performance To 31 March each year (net %)
|
2018 |
2019 |
2020 |
2021 |
2022 |
|
21.6 |
16.5 |
12.7 |
99.0 |
-9.5 |
Source: Morningstar, share price, total return.
Past performance is not a guide to future returns.
1 As at 31/03/22, five-year average annualised turnover was 9.4 per cent p.a.
2 Scottish Mortgage Carbon Footprint = 1.3tCO2e/USD invested vs 118 for FTSE All World. Scottish Mortgage Weighted Average Carbon Intensity = 11.9tCO2e/USD revenue vs 216.3 for FTSE All World. (Scope 1 and 2 for listed holdings only)
3 Tesla’s share price has fallen by over 30 per cent on seven separate occasions during the holding period
4 Scope 1 covers direct emissions from owned or controlled sources. Scope 2 covers indirect emissions from the generation of purchased electricity, steam, heating, and cooling consumed by the reporting company. Scope 3 includes all other indirect emissions that occur in a company's value chain.
5 https://www.illumina.com/company/ihope.html
The Scottish Mortgage team are dedicated to servicing existing and prospective shareholders of the trust.
This communication was produced and approved in May 2022 and has not been updated subsequently. It represents views held at the time of presentation and may not reflect current thinking.
This communication should not be considered as advice or a recommendation to buy, sell or hold a particular investment. This communication contains information on investments which does not constitute independent investment research. Accordingly, it is not subject to the protections afforded to independent research and Baillie Gifford and its staff may have dealt in the investments concerned. Investment markets and conditions can change rapidly and as such the views expressed should not be taken as statements of fact nor should reliance be placed on these views when making investment decisions.
Baillie Gifford & Co Limited is authorised and regulated by the Financial Conduct Authority. Baillie Gifford & Co Limited is the authorised Alternative Investment Fund Manager and Company Secretary of the Trust. A Key Information Document for the Scottish Mortgage Investment Trust PLC is available by contacting us.
The Scottish Mortgage Investment Trust is a listed UK company, and is not authorised or regulated by the Financial Conduct Authority. The value of its shares can fall as well as rise and investors may not get back the amount invested.
The trust invests in overseas securities. Changes in the rates of exchange may also cause the value of your investment (and any income it may pay) to go down or up.
The trust invests in emerging markets where difficulties in dealing, settlement and custody could arise, resulting in a negative impact on the value of your investment.
The trust has significant exposure to unlisted investments. The Trust’s risk could be increased as these assets may be more difficult to buy or sell, so changes in their prices may be greater.
All data is source Baillie Gifford & Co unless otherwise stated.
52429 IND WE 2013